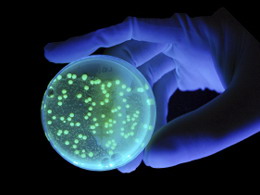
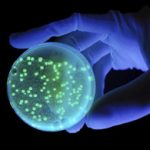

Die Novotech Unternehmensgruppe bietet eine neue Informations-Plattform für Ärzte, Heilpraktiker und Patienten im Internet an.
Nachdem die Novotech Unternehmensgruppe aus Gallneukirchen bei Linz im Frühsommer 2011 die Hersteller- und Namensrechte an dem medizintechnischen Nano-Impuls-System REHATRON™alpha übernommen hatte, stellt sie nun mit dem neuen Web-Portal www.rehatron-alpha.eu eine zentrale Informationsplattform für bestehende Therapieanwender, interessierte Ärzte und Therapeuten sowie auch für Patientenund deren Angehörige zur Verfügung.
Das Therapiesystem REHATRON™alpha, 2005 nach mehrjähriger Entwicklungsarbeit klinisch evaluiert und als erstes Nano-Impuls-Systemweltweit medizinisch sowie technisch im Geltungsbereich der „Nicht-invasiven Induktions-Therapie“ zugelassen, erzeugt äußerst starke, bipolar magnetische Impulse, die das Transmembranpotential organischer Zellen in kürzester Zeiteffektiv vergrößern können. Die elektromagnetischen Impulse, die von extremkurzer Dauer sind, werden über eine Behandlungsschlaufe nicht-invasiv und sicher an den menschlichen oder auch tierischen Organismus abgegeben. Diese Impulse erzeugen Bioenergien höchster Stufe, ohne Hitze im Gewebe selbst zu erzeugen und können erkrankten bzw. entarteten Zellen und Zellverbänden „Hilfe zur Selbsthilfe“ anbieten. Da nahezu alle Erkrankungen bei Mensch und Tier mitgestörten Zellmembranpotentialen zusammenhängen, ist die Indikationsbandbreite, bei der REHATRON™alpha als zentrale oder additive Therapieform angewendetwerden kann, entsprechend groß.
„Dank der Informationen und Berichte, die uns regelmäßig von jenen Ärzten und Therapeuten erreichen, die mit Rehatron arbeiten, wissen wir, dass wir mit dieser Therapieform einen wichtigen Beitrag für die Behandlungen zahlreicher Krankheiten leisten können,“ sagt Helmut Haller, Geschäftsführer und Inhaber der Novotech Unternehmensgruppe. „Deshalb haben wir beschlossen, über REHATRON™alpha künftig offensiver zu informieren, denn vielen Menschen, auch Ärzten und Therapeuten, ist diese Behandlungsmethode leider noch gar nichtbekannt.“
Mit dem neuen Web-Portal www.rehatron-alpha.eu ist jetzt ein erster Schritt getan worden. Neben allgemeinen Informationen rund um die Therapieform selbst, bietet das neue Webportal erstmals auch Patienten und deren Angehörigen eine leichtnavigierbare Übersicht über alle mit REHATRON™alpha arbeitenden Anwender, andie sie sich „per Mausklick“ auf deren Websites oder natürlich auch persönlich wenden können. Dieser Bereich wird in den nächsten Wochen mit weiterführenden Informationen über die individuellen Angebote und die weiteren Tätigkeitsfelderder einzelnen Ärzte, Kliniken und Therapeuten ausgebaut.
Für die Anwender selbst stehen in Kürze über einen Log-In-Bereich weitere Informationen wie z. B. der Fortlauf der zwischenzeitlich angelaufenen klinischen Studien, die gesamte Dokumentation der klinischen Bewertung sowie Fachaufsätze und Berichte von Medizinern und Wissenschaftlern uvm. zur Verfügung.
„Selbstverständlich bildet unser neuer Webauftritt zunächst nur eine grobe Übersicht zur Nicht-invasiven Induktions-Therapie mit Rehatron und ist als Phase 1 anzusehen“, erklärt Helmut Haller. „Aber wir werden gemeinsam mit unseren Partnern und den Anwendern in den kommenden Monaten eine Vielzahl von weiteren Informationen für die Öffentlichkeit anbieten. Unser Ziel ist es hierbei, diese wirklich sinnvolle, den erkrankten Organismus nicht schwächende, sondern stattdessen aufbauende Therapieform zu kommunizieren, der auch immermehr Schulmediziner erst ungläubig, aber dann begeistert eine Lanze brechen.“
Weitere Informationen sind auf www.rehatron-alpha.eu sowie auf den Websites der mit REHATRON™alpha arbeitenden Ärzten, Kliniken und Therapeuten zu finden.